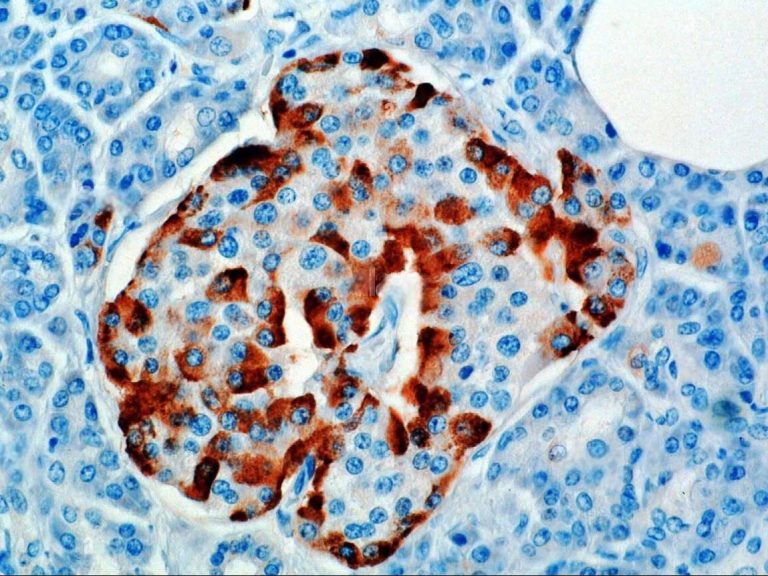

核心优势

疾病模型构建
定制基因编辑动物模型、患者来源类器官(PDO),精准模拟神经退行性疾病、肿瘤微环境、心血管病理特征等复杂疾病表型
机制深度解析
通过单细胞测序、空间转录组、分子互作分析等技术,揭示疾病关键靶点与信号通路网络
药效多维评价
结合行为学检测(如认知功能评估)、影像学分析(显微CT/MRI)、分子标记物验证及临床前安全性测试,加速创新疗法开发
个性化方案
结合行为学检测(如认知功能评估)、影像学分析(显微CT/MRI)、分子标记物验证及临床前安全性测试,加速创新疗法开发
服务一览

神经疾病研究实验服务
针对阿尔茨海默病、帕金森病、渐冻症等神经疾病,赛业生物开发一系列基因编辑小鼠模型,同时针对研究人员的需求,也可定制或合作开发基因编辑小鼠模型,如基因敲除、基因敲入、点突变、人源化小鼠模型及大小鼠手术疾病模型,加速神经药效学验证实验的开展……..

心血管疾病研究实验服务
针对阿尔茨海默病、帕金森病、渐冻症等神经疾病,赛业生物开发一系列基因编辑小鼠模型,同时针对研究人员的需求,也可定制或合作开发基因编辑小鼠模型,如基因敲除、基因敲入、点突变、人源化小鼠模型及大小鼠手术疾病模型,加速神经药效学验证实验的开展……..

呼吸疾病研究实验服务
针对阿尔茨海默病、帕金森病、渐冻症等神经疾病,赛业生物开发一系列基因编辑小鼠模型,同时针对研究人员的需求,也可定制或合作开发基因编辑小鼠模型,如基因敲除、基因敲入、点突变、人源化小鼠模型及大小鼠手术疾病模型,加速神经药效学验证实验的开展……..

消化疾病研究实验服务
针对阿尔茨海默病、帕金森病、渐冻症等神经疾病,赛业生物开发一系列基因编辑小鼠模型,同时针对研究人员的需求,也可定制或合作开发基因编辑小鼠模型,如基因敲除、基因敲入、点突变、人源化小鼠模型及大小鼠手术疾病模型,加速神经药效学验证实验的开展……..

内分泌疾病研究实验服务
针对阿尔茨海默病、帕金森病、渐冻症等神经疾病,赛业生物开发一系列基因编辑小鼠模型,同时针对研究人员的需求,也可定制或合作开发基因编辑小鼠模型,如基因敲除、基因敲入、点突变、人源化小鼠模型及大小鼠手术疾病模型,加速神经药效学验证实验的开展……..

生殖疾病研究实验服务
针对阿尔茨海默病、帕金森病、渐冻症等神经疾病,赛业生物开发一系列基因编辑小鼠模型,同时针对研究人员的需求,也可定制或合作开发基因编辑小鼠模型,如基因敲除、基因敲入、点突变、人源化小鼠模型及大小鼠手术疾病模型,加速神经药效学验证实验的开展……..

感官疾病研究实验服务
针对阿尔茨海默病、帕金森病、渐冻症等神经疾病,赛业生物开发一系列基因编辑小鼠模型,同时针对研究人员的需求,也可定制或合作开发基因编辑小鼠模型,如基因敲除、基因敲入、点突变、人源化小鼠模型及大小鼠手术疾病模型,加速神经药效学验证实验的开展……..

免疫疾病研究实验服务
针对阿尔茨海默病、帕金森病、渐冻症等神经疾病,赛业生物开发一系列基因编辑小鼠模型,同时针对研究人员的需求,也可定制或合作开发基因编辑小鼠模型,如基因敲除、基因敲入、点突变、人源化小鼠模型及大小鼠手术疾病模型,加速神经药效学验证实验的开展……..

运动疾病研究实验服务
针对阿尔茨海默病、帕金森病、渐冻症等神经疾病,赛业生物开发一系列基因编辑小鼠模型,同时针对研究人员的需求,也可定制或合作开发基因编辑小鼠模型,如基因敲除、基因敲入、点突变、人源化小鼠模型及大小鼠手术疾病模型,加速神经药效学验证实验的开展……..
皮肤疾病研究实验服务
针对阿尔茨海默病、帕金森病、渐冻症等神经疾病,赛业生物开发一系列基因编辑小鼠模型,同时针对研究人员的需求,也可定制或合作开发基因编辑小鼠模型,如基因敲除、基因敲入、点突变、人源化小鼠模型及大小鼠手术疾病模型,加速神经药效学验证实验的开展……..

肿瘤研究实验服务
针对阿尔茨海默病、帕金森病、渐冻症等神经疾病,赛业生物开发一系列基因编辑小鼠模型,同时针对研究人员的需求,也可定制或合作开发基因编辑小鼠模型,如基因敲除、基因敲入、点突变、人源化小鼠模型及大小鼠手术疾病模型,加速神经药效学验证实验的开展……..

其它疾病研究实验服务
针对阿尔茨海默病、帕金森病、渐冻症等神经疾病,赛业生物开发一系列基因编辑小鼠模型,同时针对研究人员的需求,也可定制或合作开发基因编辑小鼠模型,如基因敲除、基因敲入、点突变、人源化小鼠模型及大小鼠手术疾病模型,加速神经药效学验证实验的开展……..

基础研究实验服务
专业的临床研究实验设计与执行,确保研究数据的准确性和可靠性

医学科研方案服务
定制化科研方案设计,助力医学研究突破创新

实验平台
先进的实验设备与技术支持平台,提供全方位科研服务
